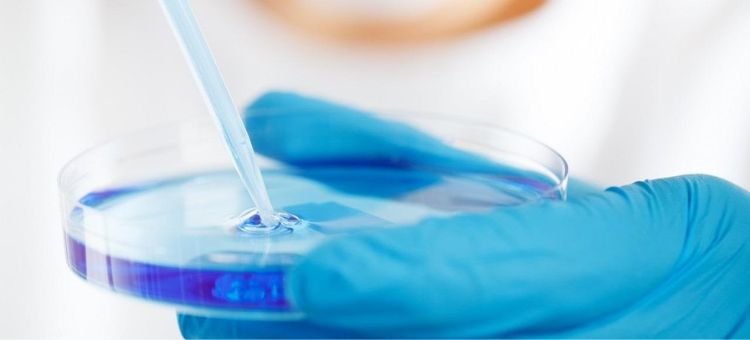

O Biobanco do Centro Académico Clínico de Coimbra CHUC-UC
- 31 outubro 2022, segunda-feira
- Gestão
FOTO PUBLICDOMAINPICTURES/ PIXABAY
O Centro Hospitalar e Universitário de Coimbra (CHUC) e a Universidade de Coimbra (UC), através do consórcio Centro Académico Clínico de Coimbra (CACC CHUC-UC), no qual a Faculdade de Medicina da Universidade de Coimbra (FMUC) ocupa uma posição privilegiada, concretizaram recentemente um projeto da maior relevância para a afirmação de Coimbra como polo de produção e difusão de conhecimento na área da saúde, e da Região Centro como sede de um dos mais importantes clusters na Europa.
Trata-se da inauguração do Biobanco CACC CHUC-UC, que ocorreu no passado dia 19 de setembro, estrutura que permita coletar e armazenar amostras biológicas com elevado padrão de qualidade, devidamente anonimizadas, de forma a poderem vir a ser disponibilizadas para fins de investigação científica, à comunidade científica local, nacional e internacional.
Em breve o Biobanco do CACC terá ainda a capacidade de proceder à caracterização celular e molecular das amostras, tornando estas coleções ainda mais atrativas para a comunidade científica e reforçando ainda mais a investigação clínica e translacional, de elevada qualidade, em associação com a formação superior e a prestação de cuidados de saúde de excelência”, podia ler-se na nota distribuída à comunicação social.
Esta nova estrutura dispôs de um financiamento de cerca de 500 mil euros, através da reprogramação de um projeto da Universidade de Coimbra, tendo sido a reabilitação do seu espaço físico financiada pelo CHUC, num valor de investimento idêntico, assegurando assim equidade no esforço de financiamento.
Esta, como outras realizações que o CHUC, a UC e o CACC têm vindo a concretizar e de que é exemplo a recente aquisição de duas PET, uma colocada no ICNAS e outra no CHUC (a primeira PET digital no SNS), no âmbito da rede científica BIN (Rede Nacional de Imagiologia Funcional Cerebral), só são possíveis graças à partilha de uma visão estratégica, entre a UC, o CHUC e o consórcio que as une, orientada para o avanço clínico, científico e tecnológico como motor do desenvolvimento económico, social e cultural do país. (...)
Administrador Hospitalar
Se quiser colocar alguma questão, envie-me um email para info@tecnohospital.pt
Outros artigos que lhe podem interessar